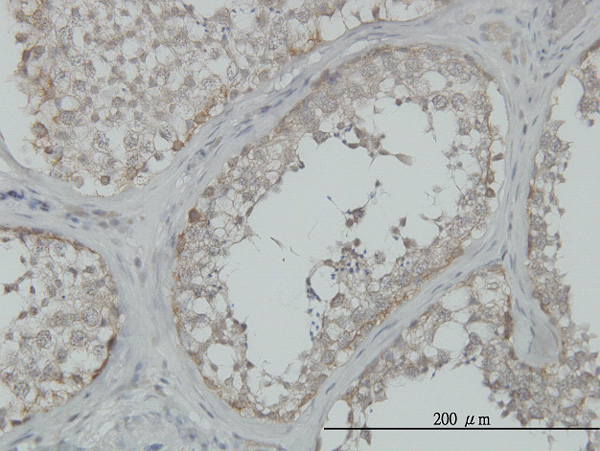

MAP3K4 Antibody (monoclonal) (M02)
Mouse monoclonal antibody raised against a partial recombinant MAP3K4.
- 产品详情
- 实验流程
- 背景知识
Application
| WB, IHC |
|---|---|
| Primary Accession | Q9Y6R4 |
| Other Accession | NM_005922 |
| Reactivity | Human, Mouse |
| Host | mouse |
| Clonality | monoclonal |
| Isotype | IgG1 Kappa |
| Clone Names | 6C6 |
| Calculated MW | 181685 Da |
| Gene ID | 4216 |
|---|---|
| Other Names | Mitogen-activated protein kinase kinase kinase 4, MAP three kinase 1, MAPK/ERK kinase kinase 4, MEK kinase 4, MEKK 4, MAP3K4, KIAA0213, MAPKKK4, MEKK4, MTK1 |
| Target/Specificity | MAP3K4 (NP_005913, 1201 a.a. ~ 1300 a.a) partial recombinant protein with GST tag. MW of the GST tag alone is 26 KDa. |
| Dilution | WB~~1:500~1000 IHC~~1:100~500 |
| Format | Clear, colorless solution in phosphate buffered saline, pH 7.2 . |
| Storage | Store at -20°C or lower. Aliquot to avoid repeated freezing and thawing. |
| Precautions | MAP3K4 Antibody (monoclonal) (M02) is for research use only and not for use in diagnostic or therapeutic procedures. |
For Research Use Only. Not For Use In Diagnostic Procedures.
Provided below are standard protocols that you may find useful for product applications.
BACKGROUND
The central core of each mitogen-activated protein kinase (MAPK) pathway is a conserved cascade of 3 protein kinases: an activated MAPK kinase kinase (MAPKKK) phosphorylates and activates a specific MAPK kinase (MAPKK), which then activates a specific MAPK. While the ERK MAPKs are activated by mitogenic stimulation, the CSBP2 and JNK MAPKs are activated by environmental stresses such as osmotic shock, UV irradiation, wound stress, and inflammatory factors. This gene encodes a MAPKKK, the MEKK4 protein, also called MTK1. This protein contains a protein kinase catalytic domain at the C terminus. The N-terminal nonkinase domain may contain a regulatory domain. Expression of MEKK4 in mammalian cells activated the CSBP2 and JNK MAPK pathways, but not the ERK pathway. In vitro kinase studies indicated that recombinant MEKK4 can specifically phosphorylate and activate PRKMK6 and SERK1, MAPKKs that activate CSBP2 and JNK, respectively but cannot phosphorylate PRKMK1, an MAPKK that activates ERKs. MEKK4 is a major mediator of environmental stresses that activate the CSBP2 MAPK pathway, and a minor mediator of the JNK pathway. Two alternatively spliced transcripts encoding distinct isoforms have been described.
REFERENCES
Incorporating age at onset of smoking into genetic models for nicotine dependence: evidence for interaction with multiple genes. Grucza RA, et al. Addict Biol, 2010 Jul. PMID 20624154.Role of mitogen-activated protein kinase kinase 4 in cancer. Whitmarsh AJ, et al. Oncogene, 2007 May 14. PMID 17496914.CIN85 regulates the ability of MEKK4 to activate the p38 MAP kinase pathway. Aissouni Y, et al. Biochem Biophys Res Commun, 2005 Dec 16. PMID 16256071.MEKK4 is an effector of the embryonic TRAF4 for JNK activation. Abell AN, et al. J Biol Chem, 2005 Oct 28. PMID 16157600.Angiotensin II stimulated transcription of cyclooxygenase II is regulated by a novel kinase cascade involving Pyk2, MEKK4 and annexin II. Derbyshire ZE, et al. Mol Cell Biochem, 2005 Mar. PMID 15881658.
终于等到您。ABCEPTA(百远生物)抗体产品。
点击下方“我要评价 ”按钮提交您的反馈信息,您的反馈和评价是我们最宝贵的财富之一,
我们将在1-3个工作日内处理您的反馈信息。
如有疑问,联系:0512-88856768 tech-china@abcepta.com.























 癌症的基本特征包括细胞增殖、血管生成、迁移、凋亡逃避机制和细胞永生等。找到癌症发生过程中这些通路的关键标记物和对应的抗体用于检测至关重要。
癌症的基本特征包括细胞增殖、血管生成、迁移、凋亡逃避机制和细胞永生等。找到癌症发生过程中这些通路的关键标记物和对应的抗体用于检测至关重要。 为您推荐一个泛素化位点预测神器——泛素化分析工具,可以为您的蛋白的泛素化位点作出预测和评分。
为您推荐一个泛素化位点预测神器——泛素化分析工具,可以为您的蛋白的泛素化位点作出预测和评分。 细胞自噬受体图形绘图工具为你的蛋白的细胞受体结合位点作出预测和评分,识别结合到自噬通路中的蛋白是非常重要的,便于让我们理解自噬在正常生理、病理过程中的作用,如发育、细胞分化、神经退化性疾病、压力条件下、感染和癌症。
细胞自噬受体图形绘图工具为你的蛋白的细胞受体结合位点作出预测和评分,识别结合到自噬通路中的蛋白是非常重要的,便于让我们理解自噬在正常生理、病理过程中的作用,如发育、细胞分化、神经退化性疾病、压力条件下、感染和癌症。